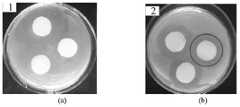

CN112831917A - Preparation method of PBC/PLA/TP composite antibacterial dressing - Google Patents
Preparation method of PBC/PLA/TP composite antibacterial dressingDownload PDFInfo
- Publication number
- CN112831917A CN112831917ACN202011622704.4ACN202011622704ACN112831917ACN 112831917 ACN112831917 ACN 112831917ACN 202011622704 ACN202011622704 ACN 202011622704ACN 112831917 ACN112831917 ACN 112831917A
- Authority
- CN
- China
- Prior art keywords
- pla
- pbc
- preparation
- composite antibacterial
- antibacterial dressing
- Prior art date
- Legal status (The legal status is an assumption and is not a legal conclusion. Google has not performed a legal analysis and makes no representation as to the accuracy of the status listed.)
- Pending
Links
Images
Classifications
- D—TEXTILES; PAPER
- D04—BRAIDING; LACE-MAKING; KNITTING; TRIMMINGS; NON-WOVEN FABRICS
- D04H—MAKING TEXTILE FABRICS, e.g. FROM FIBRES OR FILAMENTARY MATERIAL; FABRICS MADE BY SUCH PROCESSES OR APPARATUS, e.g. FELTS, NON-WOVEN FABRICS; COTTON-WOOL; WADDING ; NON-WOVEN FABRICS FROM STAPLE FIBRES, FILAMENTS OR YARNS, BONDED WITH AT LEAST ONE WEB-LIKE MATERIAL DURING THEIR CONSOLIDATION
- D04H1/00—Non-woven fabrics formed wholly or mainly of staple fibres or like relatively short fibres
- D04H1/70—Non-woven fabrics formed wholly or mainly of staple fibres or like relatively short fibres characterised by the method of forming fleeces or layers, e.g. reorientation of fibres
- D04H1/72—Non-woven fabrics formed wholly or mainly of staple fibres or like relatively short fibres characterised by the method of forming fleeces or layers, e.g. reorientation of fibres the fibres being randomly arranged
- D04H1/728—Non-woven fabrics formed wholly or mainly of staple fibres or like relatively short fibres characterised by the method of forming fleeces or layers, e.g. reorientation of fibres the fibres being randomly arranged by electro-spinning
- D—TEXTILES; PAPER
- D04—BRAIDING; LACE-MAKING; KNITTING; TRIMMINGS; NON-WOVEN FABRICS
- D04H—MAKING TEXTILE FABRICS, e.g. FROM FIBRES OR FILAMENTARY MATERIAL; FABRICS MADE BY SUCH PROCESSES OR APPARATUS, e.g. FELTS, NON-WOVEN FABRICS; COTTON-WOOL; WADDING ; NON-WOVEN FABRICS FROM STAPLE FIBRES, FILAMENTS OR YARNS, BONDED WITH AT LEAST ONE WEB-LIKE MATERIAL DURING THEIR CONSOLIDATION
- D04H1/00—Non-woven fabrics formed wholly or mainly of staple fibres or like relatively short fibres
- D04H1/40—Non-woven fabrics formed wholly or mainly of staple fibres or like relatively short fibres from fleeces or layers composed of fibres without existing or potential cohesive properties
- D04H1/42—Non-woven fabrics formed wholly or mainly of staple fibres or like relatively short fibres from fleeces or layers composed of fibres without existing or potential cohesive properties characterised by the use of certain kinds of fibres insofar as this use has no preponderant influence on the consolidation of the fleece
- D04H1/4382—Stretched reticular film fibres; Composite fibres; Mixed fibres; Ultrafine fibres; Fibres for artificial leather
- D—TEXTILES; PAPER
- D04—BRAIDING; LACE-MAKING; KNITTING; TRIMMINGS; NON-WOVEN FABRICS
- D04H—MAKING TEXTILE FABRICS, e.g. FROM FIBRES OR FILAMENTARY MATERIAL; FABRICS MADE BY SUCH PROCESSES OR APPARATUS, e.g. FELTS, NON-WOVEN FABRICS; COTTON-WOOL; WADDING ; NON-WOVEN FABRICS FROM STAPLE FIBRES, FILAMENTS OR YARNS, BONDED WITH AT LEAST ONE WEB-LIKE MATERIAL DURING THEIR CONSOLIDATION
- D04H3/00—Non-woven fabrics formed wholly or mainly of yarns or like filamentary material of substantial length
- D04H3/005—Synthetic yarns or filaments
- D—TEXTILES; PAPER
- D04—BRAIDING; LACE-MAKING; KNITTING; TRIMMINGS; NON-WOVEN FABRICS
- D04H—MAKING TEXTILE FABRICS, e.g. FROM FIBRES OR FILAMENTARY MATERIAL; FABRICS MADE BY SUCH PROCESSES OR APPARATUS, e.g. FELTS, NON-WOVEN FABRICS; COTTON-WOOL; WADDING ; NON-WOVEN FABRICS FROM STAPLE FIBRES, FILAMENTS OR YARNS, BONDED WITH AT LEAST ONE WEB-LIKE MATERIAL DURING THEIR CONSOLIDATION
- D04H3/00—Non-woven fabrics formed wholly or mainly of yarns or like filamentary material of substantial length
- D04H3/02—Non-woven fabrics formed wholly or mainly of yarns or like filamentary material of substantial length characterised by the method of forming fleeces or layers, e.g. reorientation of yarns or filaments
- D—TEXTILES; PAPER
- D10—INDEXING SCHEME ASSOCIATED WITH SUBLASSES OF SECTION D, RELATING TO TEXTILES
- D10B—INDEXING SCHEME ASSOCIATED WITH SUBLASSES OF SECTION D, RELATING TO TEXTILES
- D10B2505/00—Industrial
- D10B2505/04—Filters
- D—TEXTILES; PAPER
- D10—INDEXING SCHEME ASSOCIATED WITH SUBLASSES OF SECTION D, RELATING TO TEXTILES
- D10B—INDEXING SCHEME ASSOCIATED WITH SUBLASSES OF SECTION D, RELATING TO TEXTILES
- D10B2509/00—Medical; Hygiene
Landscapes
- Engineering & Computer Science (AREA)
- Textile Engineering (AREA)
- Pharmaceuticals Containing Other Organic And Inorganic Compounds (AREA)
- Materials For Medical Uses (AREA)
Abstract
Description
Technical Field
The invention relates to a preparation method of PBC/PLA/TP composite antibacterial dressing, belonging to the technical field of modification of electrospun fiber membranes.
Background
In recent years, degradable materials have attracted increasing attention, both from the viewpoint of environmental protection and from the viewpoint of convenience in use. In particular, biomedical materials are widely researched to avoid the need of secondary operations, drug release and enzyme carriers. Among them, the degradable polyester materials have been the hot spots due to their characteristics of good biocompatibility, good mechanical strength, innocuity and easy discharge of the degradation products, especially Polycaprolactone (PCA) has received great attention.
The application of medical dressings to the skin wound surface is an effective solution to the above-mentioned problems. Because it can guarantee to separate wound and external harmful microorganism, reduced the wound infection that the wound received the microorganism invasion and led to greatly to the healing of wound is accelerated. The traditional medical dressing is cotton gauze, has the main functions of stopping bleeding, sterilizing and absorbing wound surface exudate, and has the defect that the dressing is easy to adhere to a wound surface and is easy to cause secondary injury; the gauze has strong air permeability, so that the wound cannot be better protected from being contacted with the outside, and the probability of wound infection is higher; in addition, conventional dressings are used in large quantities and require frequent replacement. In the modern times, degradable high polymer materials are adopted to replace the traditional gauze to manufacture medical dressings, but the technology of the degradable high polymer medical dressings is immature, so that the degradable high polymer medical dressings have the defects of poor antibacterial effect, low degradation rate, poor biocompatibility, poor mechanical property and the like.
PLA (polylactic acid) is a high molecular material prepared by fermenting biomass materials containing sugar, starch, cellulose and the like serving as raw materials to prepare lactic acid and polymerizing the lactic acid, can be recycled from wastes, has the characteristics of good biocompatibility, excellent degradability and the like, and is one of a few biodegradable and recyclable resins at present. However, the toughness of PLA is greatly limited due to the slow biodegradation rate, high cost and low impact strength of PLA.
Therefore, the completely biodegradable material with better antibacterial property and mechanical property has important significance.
Disclosure of Invention
In order to overcome the defects of the prior art, the invention provides the preparation method of the PBC/PLA/TP composite antibacterial dressing, which has the advantages of simple operation, low cost, excellent mechanical property of the prepared product, short degradation time and no pollution of wastes.
The preparation method of the PBC/PLA/TP composite antibacterial dressing comprises the following steps:
(1) drying PBC, PLA and TP for later use;
(2) PBC, PLA, TP and the medicine are added into a solvent, and the mixture is heated and stirred for 2 to 7 hours at the temperature of between 40 and 80 ℃ to obtain a spinning solution;
(3) and (3) carrying out electrostatic spinning on the spinning solution, and preparing the antibacterial PBC/PLA/TP composite fiber membrane by adopting a roller collection method.
In the step (1), the drying temperature is 30-60 ℃, and the drying time is 4-12 hours.
In the step (2), the solvent is one or a mixture of two of trifluoroacetic acid (TFA), Dichloromethane (DCM), N-Dimethylformamide (DMF), Tetrahydrofuran (THF) and glacial acetic acid (acetic acid).
In the step (2), the mass ratio of PBC, PLA and TP is 0.1-3: 0.1-3: 0.001-0.05.
In the step (2), the medicament is one of ciprofloxacin hydrochloride, moxifloxacin hydrochloride, levofloxacin hydrochloride or clindamycin hydrochloride.
In the step (2), the addition amount of the medicine is 0.0001-0.001 g.
The inner diameter of the nozzle of the electrostatic spinning injector is 0.1-1.0 mm.
The process conditions during electrostatic spinning are as follows: the voltage is 10-20kV, the flow is 0.01-1.00mL/h, and the receiving distance is 10-15 cm.
The fiber diameter of the composite fiber membrane prepared by the method is 300-500 nm.
The composite fiber membrane prepared by the invention can be used for various different purposes, such as being used as a water filtering membrane; preparing an air filter screen for air filtration; preparing into biomedical film materials and the like.
In the invention, the polylactic acid and the PBC have good biocompatibility, so that TP can better exchange substances with wounds, and the release amount of the medicament can be better controlled, thereby achieving the effect of medicament slow release.
Compared with the prior art, the invention has the following beneficial effects:
(1) the composite antibacterial dressing prepared by the invention has good biocompatibility and antibacterial activity;
(2) according to the invention, products with different fiber diameters, thicknesses and functions can be prepared by changing electrospinning parameters, the prepared fiber membrane material has good mechanical strength, the preparation process is simple to operate, and the cost is low;
(3) the raw material of the polybutylene carbonate has higher degradation speed, and after the polybutylene carbonate is prepared into the electrospun fiber membrane with the ultrahigh specific surface area, the waste can be degraded into carbon dioxide and water in a shorter time after being discarded, so that the environment is hardly influenced;
(4) the product prepared by the invention can be applied to biomedical use, in particular to the tissue engineering field with shorter recovery period, so that the degradation degree of the product is matched with the recovery speed of the injured part.
Drawings
FIG. 1 is SEM image and average diameter distribution diagram of PBC/PLA/TP composite antimicrobial dressing with different mass ratios of TP to PLA/PBC;
(a)PLA/PBC;
(b)10%TP-PLA/PBC;
(c)20%TP-PLA/PBC;
FIG. 2 is an infrared spectrum of the composite antimicrobial dressing before and after addition of TP;
FIG. 3 is a mechanical property test curve of the PBC/PLA/TP composite antibacterial dressing;
FIG. 4 is the contact angle of PBC/PLA/TP composite antimicrobial dressing with different mass ratios of TP to PLA/PBC;
(a)PLA/PBC;
(b)10%TP-PLA/PBC;
(c)20%TP-PLA/PBC;
FIG. 5 is a comparison graph of experimental effects of inhibition zones of PBC/PLA/TP composite antibacterial dressing with different mass ratios of TP and PLA/PBC;
(a) the product prepared in comparative example 2;
(b) the product prepared in example 1;
(c) the product prepared in example 2;
(d) the product prepared in example 3;
(e) the product prepared in example 4;
(f) the product prepared in comparative example 2;
FIG. 6 shows the inhibition width of PBC/PLA/TP composite antibacterial dressing with different mass ratios of TP and PLA/PBC;
(a)PLA/PBC;
(b)10%TP-PLA/PBC;
(c)20%TP-PLA/PBC;
FIG. 7 shows the bacteriostasis rates of PBC/PLA/TP composite antibacterial dressing with different mass ratios of TP and PLA/PBC;
(a)PLA/PBC;
(b)10%TP-PLA/PBC;
(c)20%TP-PLA/PBC。
Detailed Description
The present invention will be further described with reference to the following embodiments.
Example 1
(1) TP, PLA, PBC and moxifloxacin hydrochloride are placed into an electric heating blowing drying oven to be dried for 6 hours at the temperature of 80 ℃, so that the medicaments are kept dry;
(2) weighing PLA with the mass ratio of 2.4g and 1.2g of PBC, adding 45ml of Dichloromethane (DCM) solvent, and heating and dissolving at the temperature of 60 ℃ for 5 hours to obtain a mixed solution;
(3) weighing 0.003g and 0.0003g of processed tea polyphenol and moxifloxacin hydrochloride and the mixed solution in thestep 2, heating and dissolving for 5 hours at 40 ℃, and using for subsequent spinning;
(4) and spinning the prepared polymer solution at room temperature by using an electrostatic spinning machine to prepare the PBC/PLA/TP composite antibacterial dressing.
Example 2
(1) Putting TP, PLA, PBC and ciprofloxacin hydrochloride into an electrothermal blowing drying oven to be dried for 6 hours at the temperature of 80 ℃ so as to keep the medicine dry;
(2) weighing PLA with the mass ratio of 2.4g and PBC with the mass ratio of 1.2g, adding into 45ml of trifluoroacetic acid (TFA) solvent, and heating and dissolving at the temperature of 80 ℃ for 3 hours to obtain a mixed solution;
(3) weighing 0.001g of treated tea polyphenol, 0.0001g of ciprofloxacin hydrochloride and the mixed solution in thestep 2, heating and dissolving for 4 hours at 40 ℃, and using for subsequent spinning;
(4) and spinning the prepared polymer solution at room temperature by using an electrostatic spinning machine to prepare the PBC/PLA/TP composite antibacterial dressing.
Example 3
(1) Putting TP, PLA, PBC and ciprofloxacin hydrochloride into an electrothermal blowing drying oven to be dried for 6 hours at the temperature of 80 ℃ so as to keep the medicine dry;
(2) weighing 2.4g of PLA and 1.2g of PBC in mass ratio, and heating and dissolving the weighed PLA and PBC in a trifluoroacetic acid (TFA) solvent at the temperature of 60 ℃ for 6 hours to obtain a mixed solution;
(3) weighing 0.006g of processed tea polyphenol and 0.0003g of ciprofloxacin hydrochloride, and heating and dissolving the mixed solution in thestep 2 at 60 ℃ for 2 hours for subsequent spinning;
(4) and spinning the prepared polymer solution at room temperature by using an electrostatic spinning machine to prepare the PBC/PLA/TP composite antibacterial dressing.
Example 4
(1) Placing tea polyphenols, PLA and PBC into an electric heating blowing drying oven, and drying at 80 deg.C for 6 hr to keep the medicine dry;
(2) weighing 2.4g of PLA and 1.2g of PBC in mass ratio, and heating and dissolving the weighed PBC and Tetrahydrofuran (THF) solvent at the temperature of 40 ℃ for 6 hours to obtain a mixed solution;
(3) weighing 0.006g of processed tea polyphenol and 0.0003g of ciprofloxacin hydrochloride, and heating and dissolving the mixed solution in thestep 2 at 80 ℃ for 1 hour for subsequent spinning;
(4) and spinning the prepared polymer solution at room temperature by using an electrostatic spinning machine to prepare the PBC/PLA/TP composite antibacterial dressing.
Comparative example 1
Medical antibacterial dressing is sold in the market.
Comparative example 2
(1) Placing PLA and PBC into an electric heating blowing drying oven to dry for 6 hours at 80 ℃ so as to keep the medicines dry;
(2) weighing 1.2g of PLA and 1.2g of PBC in mass ratio, adding the PLA and the PBC into 45ml of N, N-Dimethylformamide (DMF) solvent, and heating and dissolving at the temperature of 60 ℃ for 5 hours to obtain a mixed solution;
(3) and spinning the prepared polymer solution at room temperature by using an electrostatic spinning machine to prepare the PBC/PLA composite antibacterial dressing.
The products prepared in the examples and comparative examples were subjected to the relevant tests and the results are shown in table 1.
TABLE 1 PBC/PLA/TP composite antibiotic dressing performance index
The PBC/PLA/TP composite antibacterial dressing prepared by the embodiments has antibacterial property on at least 1 of staphylococcus aureus and escherichia coli.
As can be seen from the bacteriostasis experiment in the attached figure 5, the composite antibacterial dressing has bacteriostasis effect after TP and the medicament are added. Along with the optimization of the proportion of medicine, the antibacterial zone has reached the peak value to with other medicine-carrying dressings contrast, the size of antibacterial zone has obvious promotion.
PLA/PBC is taken as a carrier, TP is taken as an additive, and the PLA/PBC/TP composite nanofiber film is blended and spun. FIG. 2 is an infrared spectrum diagram formed by a correlated characteristic peak curve A of a PLA/PBC pure sample and a correlated characteristic absorption peak curve B of a PLA/PBC/TP cospinning system. At 2967cm-1The vibration absorption peak at (A) is caused by methylene and is at 1739cm-1The absorption peaks of stretching vibration are caused by C ═ O, 1237, 1186 and 1093cm-1The absorption peak of stretching vibration of C-O-C bond exists. These are all structural characteristic absorption peaks of PBC. For PLA, the characteristic peaks that can form hydrogen bonds are: 1237. 1180 and 1088cm-1Here, they are all the C-O-C stretching vibration absorption peaks, indicating the presence of an ester group. 1459cm-1Is of the formula-CH3Has a bending vibration absorption peak at 1739cm-1Where is the stretching vibration absorption peak of C ═ O. At 2976cm-1Nearby is-CH3Together with-R-CO-OHThe structure of (a) characterizes the absorption peak. Due to the presence of associated-OH in the TP, -CH in PLA3The compound can be connected with benzene rings in TP together through combination to form a conjugated system, so that the electron cloud is densely distributed. In curve B of the IR spectrum (with the addition of TP), the range of the benzene ring absorption peak appears, indicating good biocompatibility of TP with PLA/PBC.
As can be seen from fig. 3, with the addition of TP, the elongation at break of the system increases first and then decreases, the tensile strength gradually increases in a large increase range, and when the TP proportion is 0.3%, the elongation at break of the system reaches a maximum of 109.84%. From the analysis of the structure, along with the increase of TP content, the electric field force action becomes larger, the fiber diameter is reduced, the contact area between fibers becomes larger, the structure of the fiber membrane is tighter, and meanwhile, the change also influences the interaction between the fibers, namely the mutual friction is increased, and the relative slippage is reduced. As a result, the fully biodegradable film has a low elongation at break and a high relative tensile strength. From molecular analysis, the change in the mechanical properties of the biofilm depends mainly on the breaking of chemical and hydrogen bonds and the change in van der waals forces. Because some tea polyphenol short molecular chains are embedded between PLA macromolecular chain segments, the PLA chain segments can not be fully stretched in the stretching process, thereby reducing the breaking elongation of the material film. As described above, the addition of the TP short segment increases the distance between molecular chains, and the molecular chains rotate in a sufficient space, resulting in bending and curling of the main chain. When the composite film is stretched by external force, the internal rotary molecular chain segments tend to be straightened and then are stretched, so that the improvement of the breaking elongation of the fibers is facilitated, and the breaking elongation of the composite film is increased. However, when the number of short TP molecule segments reaches a certain value, the rotation of the molecule chain is rather inhibited, and finally the elongation at break is decreased.
Of course, the foregoing is only a preferred embodiment of the invention and should not be taken as limiting the scope of the embodiments of the invention. The present invention is not limited to the above examples, and equivalent changes and modifications made by those skilled in the art within the spirit and scope of the present invention should be construed as being included in the scope of the present invention.
Claims (9)
1. A preparation method of PBC/PLA/TP composite antibacterial dressing is characterized by comprising the following steps: the method comprises the following steps:
(1) drying PBC, PLA and TP for later use;
(2) PBC, PLA, TP and the medicine are added into a solvent, and the mixture is heated and stirred for 2 to 7 hours at the temperature of between 40 and 80 ℃ to obtain a spinning solution;
(3) and (3) carrying out electrostatic spinning on the spinning solution, and preparing the antibacterial PBC/PLA/TP composite fiber membrane by adopting a roller collection method.
2. The preparation method of the PBC/PLA/TP composite antibacterial dressing according to claim 1, which is characterized in that: in the step (1), the drying temperature is 30-60 ℃, and the drying time is 4-12 hours.
3. The preparation method of the PBC/PLA/TP composite antibacterial dressing according to claim 1, which is characterized in that: in the step (2), the solvent is one or a mixed solution of two of trifluoroacetic acid, dichloromethane, N-dimethylformamide, tetrahydrofuran and glacial acetic acid.
4. The preparation method of the PBC/PLA/TP composite antibacterial dressing according to claim 1, which is characterized in that: in the step (2), the mass ratio of PBC, PLA and TP is 0.1-3: 0.1-3: 0.001-0.05.
5. The preparation method of the PBC/PLA/TP composite antibacterial dressing according to claim 1, which is characterized in that: in the step (2), the medicament is one of ciprofloxacin hydrochloride, moxifloxacin hydrochloride, levofloxacin hydrochloride or clindamycin hydrochloride.
6. The method for preparing the PBC/PLA/TP composite antibacterial dressing according to claim 5, which is characterized in that: the medicine is added in an amount of 0.0001-0.001 g.
7. The preparation method of the PBC/PLA/TP composite antibacterial dressing according to claim 1, which is characterized in that: the inner diameter of the nozzle of the electrostatic spinning injector is 0.1-1.0 mm.
8. The preparation method of the PBC/PLA/TP composite antibacterial dressing according to claim 1, which is characterized in that: the technological conditions during electrostatic spinning are as follows: the voltage is 10-20kV, the flow is 0.01-1.00mL/h, and the receiving distance is 10-15 cm.
9. The preparation method of the PBC/PLA/TP composite antibacterial dressing according to claim 1, which is characterized in that: the fiber diameter of the prepared composite fiber membrane is 300-500 nm.
Priority Applications (1)
| Application Number | Priority Date | Filing Date | Title |
|---|---|---|---|
| CN202011622704.4ACN112831917A (en) | 2020-12-30 | 2020-12-30 | Preparation method of PBC/PLA/TP composite antibacterial dressing |
Applications Claiming Priority (1)
| Application Number | Priority Date | Filing Date | Title |
|---|---|---|---|
| CN202011622704.4ACN112831917A (en) | 2020-12-30 | 2020-12-30 | Preparation method of PBC/PLA/TP composite antibacterial dressing |
Publications (1)
| Publication Number | Publication Date |
|---|---|
| CN112831917Atrue CN112831917A (en) | 2021-05-25 |
Family
ID=75924234
Family Applications (1)
| Application Number | Title | Priority Date | Filing Date |
|---|---|---|---|
| CN202011622704.4APendingCN112831917A (en) | 2020-12-30 | 2020-12-30 | Preparation method of PBC/PLA/TP composite antibacterial dressing |
Country Status (1)
| Country | Link |
|---|---|
| CN (1) | CN112831917A (en) |
Citations (4)
| Publication number | Priority date | Publication date | Assignee | Title |
|---|---|---|---|---|
| CN102787448A (en)* | 2012-07-26 | 2012-11-21 | 东华大学 | Preparation method of degradable polycarbonate butanediol ester electrospinning fiber films |
| CN108653794A (en)* | 2018-05-21 | 2018-10-16 | 江苏亿茂滤材有限公司 | A kind of preparation method of based composite dressing for medical use |
| US20200085943A1 (en)* | 2012-01-31 | 2020-03-19 | Curevac Ag | Pharmaceutical composition comprising a polymeric carrier cargo complex and at least one protein or peptide antigen |
| CN111012941A (en)* | 2020-01-10 | 2020-04-17 | 中原工学院 | Electrostatic spinning double-layer long-acting antibacterial medical dressing and preparation method thereof |
- 2020
- 2020-12-30CNCN202011622704.4Apatent/CN112831917A/enactivePending
Patent Citations (4)
| Publication number | Priority date | Publication date | Assignee | Title |
|---|---|---|---|---|
| US20200085943A1 (en)* | 2012-01-31 | 2020-03-19 | Curevac Ag | Pharmaceutical composition comprising a polymeric carrier cargo complex and at least one protein or peptide antigen |
| CN102787448A (en)* | 2012-07-26 | 2012-11-21 | 东华大学 | Preparation method of degradable polycarbonate butanediol ester electrospinning fiber films |
| CN108653794A (en)* | 2018-05-21 | 2018-10-16 | 江苏亿茂滤材有限公司 | A kind of preparation method of based composite dressing for medical use |
| CN111012941A (en)* | 2020-01-10 | 2020-04-17 | 中原工学院 | Electrostatic spinning double-layer long-acting antibacterial medical dressing and preparation method thereof |
Non-Patent Citations (1)
| Title |
|---|
| 顾晓华等: "茶多酚-聚乳酸/聚碳酸丁二醇酯抗菌复合纤维膜的制备及性能", 《复合材料学报》* |
Similar Documents
| Publication | Publication Date | Title |
|---|---|---|
| Zahedi et al. | RETRACTED: Preparation and performance evaluation of tetracycline hydrochloride loaded wound dressing mats based on electrospun nanofibrous poly (lactic acid)/poly (ϵ‐caprolactone) blends | |
| Scaffaro et al. | Processing, structure, property relationships and release kinetics of electrospun PLA/Carvacrol membranes | |
| López-Córdoba et al. | A simple green route to obtain poly (vinyl alcohol) electrospun mats with improved water stability for use as potential carriers of drugs | |
| EP2283175B1 (en) | Fibers formed from a blend of a modified aliphatic-aromatic copolyester and thermoplastic starch | |
| CN103394114B (en) | A kind of preparation method of medical dressing chitosan-based superfine fiber carrier material | |
| CN111662457B (en) | Polylactic acid grafted quaternized chitosan material and its stereocomposite crystalline nanofiber membrane and their preparation method and application | |
| CN109505031B (en) | Stereo composite crystal polylactic acid nano fiber, bacteriostatic stereo composite crystal polylactic acid nano fiber, preparation method and application thereof | |
| CN103768662B (en) | The preparation method of a kind of biodegradable medical surgery anti-adhesion membrane | |
| Felgueiras et al. | Biodegradable, spun nanocomposite polymeric fibrous dressings loaded with bioactive biomolecules for an effective wound healing: A review | |
| Cosme et al. | Development of biobased poly (lactic acid)/epoxidized natural rubber blends processed by electrospinning: morphological, structural and thermal properties | |
| Campa-Siqueiros et al. | Electrospun and co-electrospun biopolymer nanofibers for skin wounds on diabetic patients: An overview | |
| CN114989590B (en) | High-fluidity polylactic acid material | |
| CN110331579B (en) | An antibacterial surface functionalized aniline oligomer nanofiber and its preparation method and application | |
| CN113136638B (en) | Biodegradable parallel composite elastic fiber and preparation method thereof | |
| Sadeghi et al. | Matrix–drug interactions for the development of pH-sensitive alginate-based nanofibers as an advanced wound dressing | |
| Li et al. | Chitosan electrospun nanofibers derived from Periplaneta americana residue for promoting infected wound healing | |
| CN108396461B (en) | Healing-promoting nanofiber membrane dressing and preparation method thereof | |
| Irantash et al. | A hybrid structure based on silk fibroin/PVA nanofibers and alginate/gum tragacanth hydrogel embedded with cardamom extract | |
| CN113249815A (en) | Biodegradable PGA melt spinning forming method | |
| CN112831917A (en) | Preparation method of PBC/PLA/TP composite antibacterial dressing | |
| JP3304237B2 (en) | Core / sheath type biodegradable composite fiber | |
| CN109021242B (en) | PCE polymer, preparation method thereof and method for preparing antibacterial nanofiber material by using PCE polymer | |
| CN119633159A (en) | A degradable wound dressing and preparation method thereof | |
| CN115613219B (en) | Multifunctional medical material and preparation method and application thereof | |
| Lu et al. | Controlled release of tetracycline hydrochloride loaded highly absorbent alginate submicron fibers from centrifugally spinning |
Legal Events
| Date | Code | Title | Description |
|---|---|---|---|
| PB01 | Publication | ||
| PB01 | Publication | ||
| SE01 | Entry into force of request for substantive examination | ||
| SE01 | Entry into force of request for substantive examination | ||
| RJ01 | Rejection of invention patent application after publication | Application publication date:20210525 | |
| RJ01 | Rejection of invention patent application after publication |